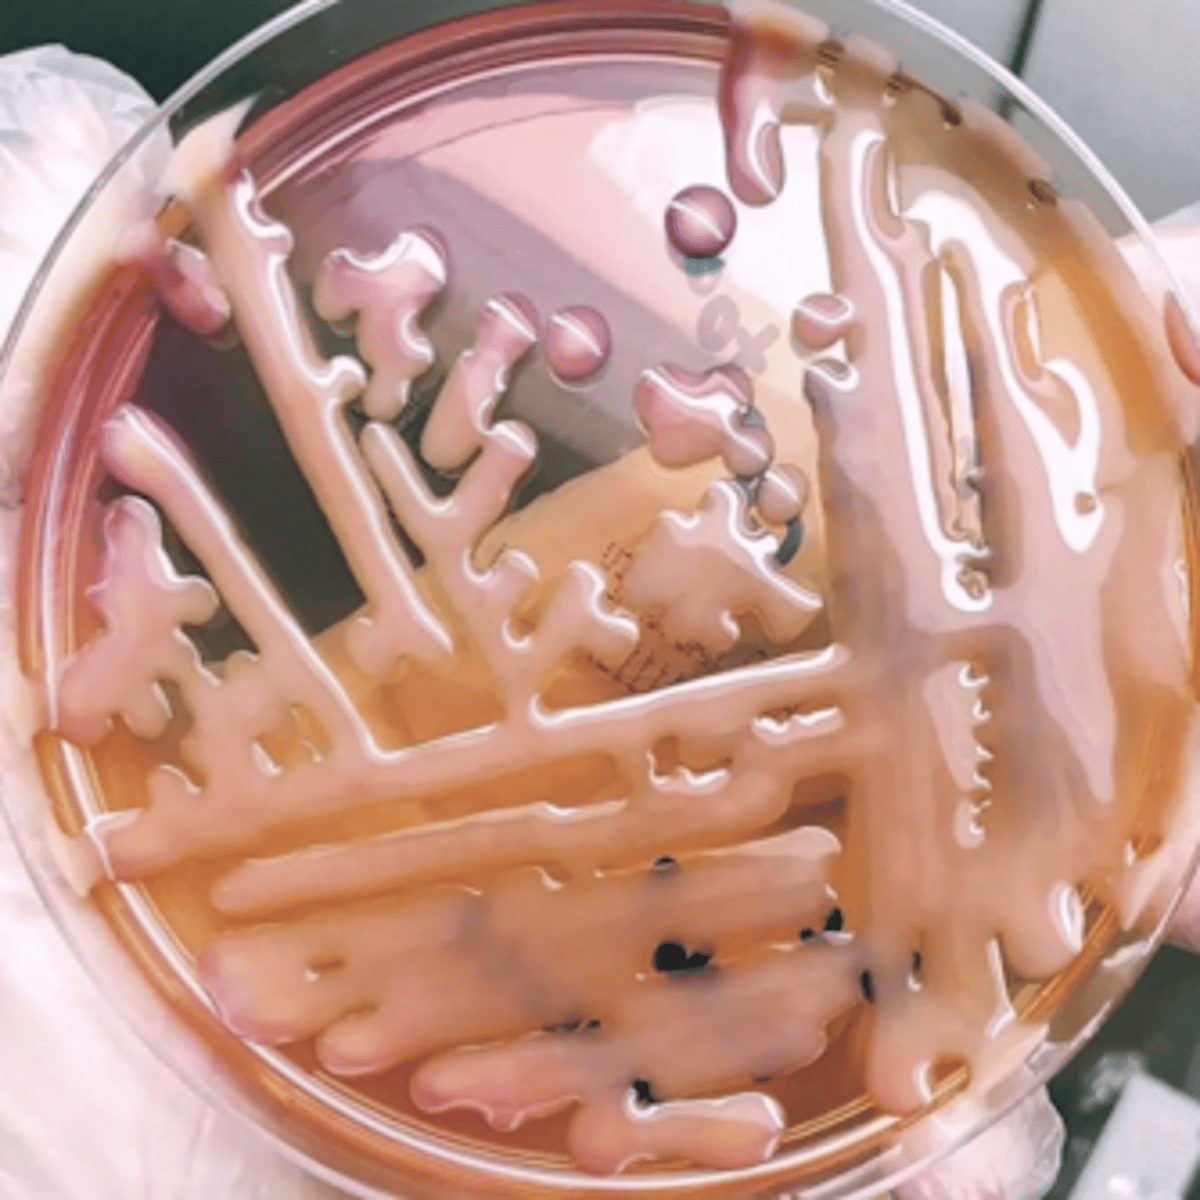
<p>what is this type of bacteria colony called that has a very thick capsule?</p>
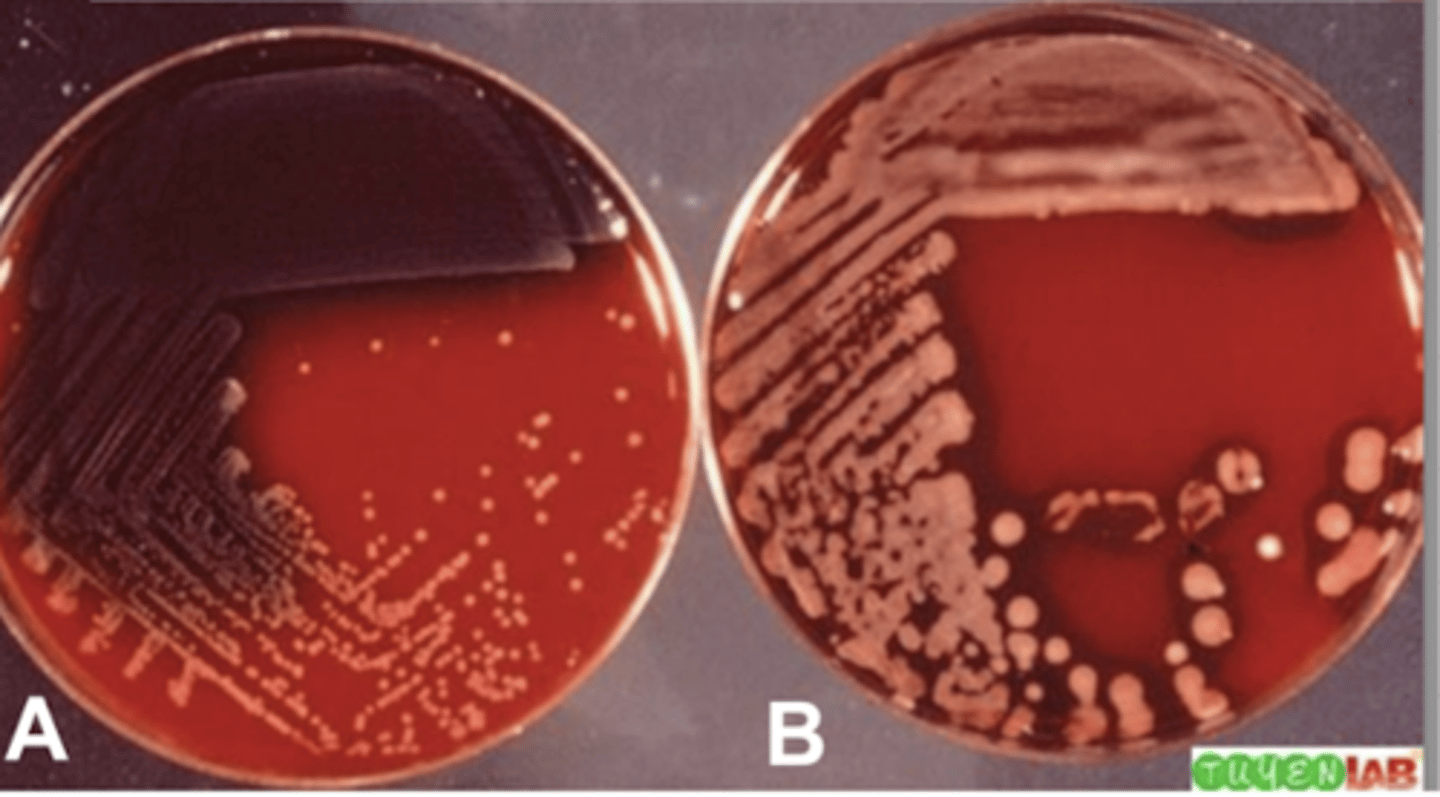
<p>which bacteria formed mucoid colonies?</p>
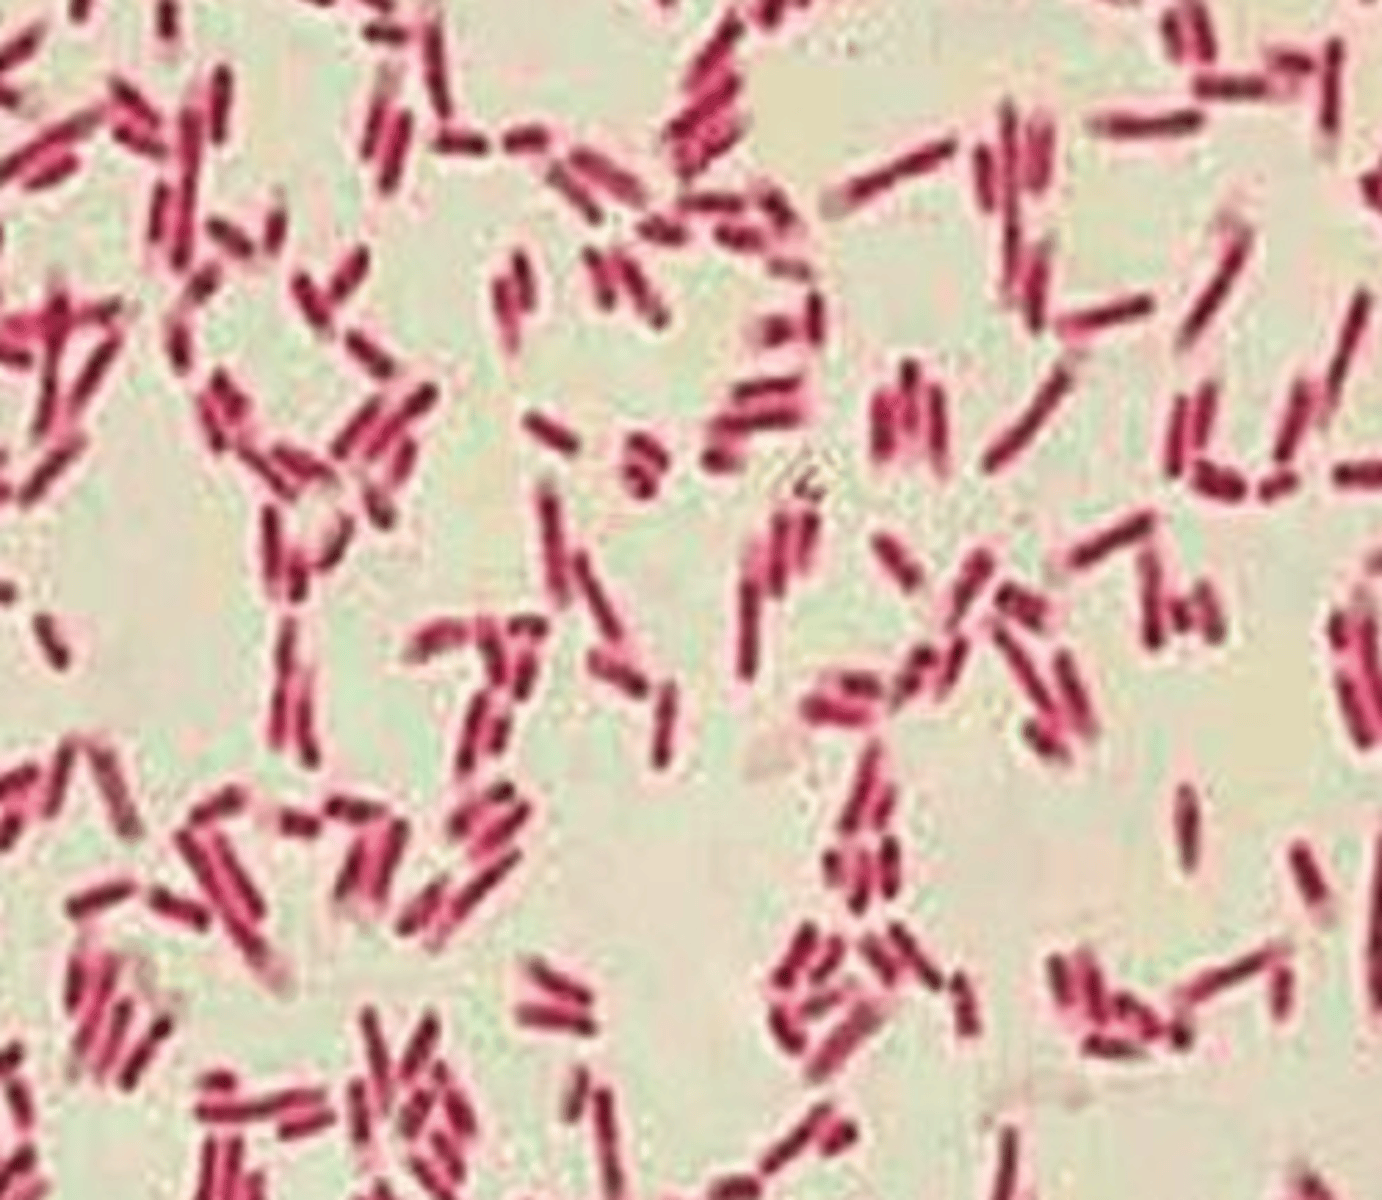
<p>coccus or rods?</p><p>G+ or G-?</p>

1/94
Looks like no tags are added yet.
Name | Mastery | Learn | Test | Matching | Spaced | Call with Kai |
|---|
No analytics yet
Send a link to your students to track their progress
100x
for bacteria, what magnification do we use when looking at the cells through a microscope?
coccus and rods
what are the 2 shapes of bacteria cells that we find?
coccus
what is the name for the bacteria cells that are shaped like circles?
capsule
what is the most external layer of the bacteria cell called?
capsule
the _______ is the most external layer of the bacteria cell
protection, allow adherence, anti-phagocytic, antigenic
what is the function of the capsule of the bacteria cell?
mucoid colonies
what type of colonies have a VERY thick capsule?
mucoid
what is this type of bacteria colony called that has a very thick capsule?
2
which bacteria formed mucoid colonies?
the capsule of the bacteria cell
what do we see here in white?

cell wall
what layer is underneath the capsule of the bacteria cell?
protection from mechanical damage, osmotic lysis
what is the function of the cell wall?
capsule
which part of the bacteria cell allows adhesion to the host?
cell wall
which part of the bacteria cell determines the color that the cells appear with the gram stain?
G+: the very thick layer of peptidoglycans traps the crystal glycan dye, and the safranin then has no effect
G-: has less peptidoglycans and an outer membrane. the crystal glycan does not stain the cell because it does not get trapped in the thin layer of peptidoglycans, and then the safranin dye stains it red after
what properties of the cell wall determine the color that the cells are stained with the gram stain?
pink/red
G- bacteria stain what color?
blue/purple
what color do G+ bacteria get stained?
G-
which bacteria- G+ or G- have an outer membrane on their cell wall?
G+
which bacteria- G+ or G- have a thicker layer of proteoglycan in their cell wall?
G+ coccus
coccus or rods?
G+ or G-?

G- rods
coccus or rods?
G+ or G-?
G- coccus
coccus or rods?
G+ or G-?

G+ rods
coccus or rods?
G+ or G-?

right, because it has an outer membrane and a thinner layer of peptidoglycans
which is G-? why?

phospholipid bilayer
the cytoplasmic membrane of bacteria cells is composed of.....
active transport of nutrients, elimination of waste, electron transport for bacterial respiration
what is the function of the cytoplasmic membrane of the bacteria cell?
nuclear material, ribosomes, nutrients, enzymes
what components are in the cytoplasm of the bacteria cell?
bacterial DNA: haploid circular chromosome
plasmids: small circular pieces of DNA
what are the 2 types of bacterial material inside the bacteria cell?
flagella
what are the structures of the bacteria cell that are used for movement?
monotrichous
what is this bacteria classified as?

lophotrichous
this bacteria is classified as....

amphitrichous
how can we classify this bacteria cell?

peritrichous
what is the classification of this bacteria cell?

1
which is monotrichous?

2
which bacteria cell is lophotrichous?

3
which bacteria cell is amphitrichous?

4
which bacteria cell is peritrichous?

short, thick surfaces appendages that are used for adhesion
what are pilli?
flagella
which, pilli, or flagella are used for movement?
pilli
which- pilli or flagella, are used for adhesion?
adhesion
what is the function of pilli?
endospores
what are produced by some bacteria when environmental conditions are very poor?
highly resistant dormant structures that are formed by some bacteria when the environmental conditions are too poor for the bacteria to survive
what are endospores?
1. DNA is replicated
2. DNA aligns along the cell axis
3. cytoplasmic membrane invaginates the form the forespore
4. cytoplasmic membrane grows and engulfs forespore within a second membrane. the vegetative cell's DNA disintegrates
5. a cortex of calcium and dipicolinic acid is deposited between the membranes
6. spore coat forms around endospores
7. maturation of endospore: completion of spore coat and increase in resistance to heat and chemicals
8. endospore released from the original cell
describe the process of endospore formation
an endotoxin produced by G- bacteria that inhibits the complement
what is the O antigen polysaccharide chain?
exotoxins
what type of toxins are produced by G+ bacteria?
yes
do G+ bacteria produce exotoxins?
no
do G+ bacteria produce endotoxins?
both endotoxins and exotoxins
what type of toxins are produced by G- bacteria?
endotoxins
which toxins- endotoxins or exotoxins are pyogenic?
exotoxins
which type of toxins- exotoxins or endotoxins are released by live bacteria?
endotoxins
which type of toxins- exotoxins or endotoxins are released by when the bacteria cell dies?
endotoxins
which type of toxins- exotoxins or endotoxins are a part of the cell wall?
exotoxins
which type of toxins- exotoxins or endotoxins are highly antigenic?
exotoxins
which type of toxins- exotoxins or endotoxins are denatured with heat?
exotoxins
which type of toxins- exotoxins or endotoxins have more specific activity?
bacteria suspended in fluid, some bacteria we can see moving
when we use dark-field microscopy, what do we see?
inoculated directly into cultural media or placed in a preenrichment culture that has nutrients to recover them
after sample collection, the bacteria is placed in a transport medium, where it can be either.....
1. exponential phase
2. stationary phase
3. decline phase
what are the 3 stages of bacterial growth?

# of bacteria dividing > # of bacteria dying
explain what is occurring during the exponential phase (1)?

# of bacteria dividing = # of bacteria dying
which is the stationary phase? what is happening with the bacteria here?

2- stationary phase
which is the good moment to reinoculate the bacteria into a new cultural media with new nutrients to allow them to continue growing rather than die?

decline phase- # bacteria dividing < # of bacteria dying
what is 3? what is happening with the bacteria?

reinoculate the bacteria into a new cultural media to give it new nutrients and continue the growth
what can we do in order to avoid the decline phase (3)?

1. organic sources (for heterotrophic bact.) or CO2 (for autotrophic bact.)
2. peptones
what nutrition do bacteria need to grow?
nutrient
most bacteria can grow in _____ agar
allows the differentiation of hemolytic and non hemolytic bacteria
what is the purpose of using blood agar?
they grow at 30-37 degrees
all the G+ bacteria we study are mesophiles, what does this mean?
7
what pH do bacteria need to grow?
2- most external layer
where is the capsule?

cytoplasm
what is 1?

3
where is the cell wall?

cytoplasmic membrane
what is 4?

pilli
what is 6?

8
where is the flagella?

nucleoid
what is 7?

no
are all bacteria aerobic?
1- because it it growing close to the top, where the oxygen is
which bacteria is obligate aerobic?

2- because it is growing far from the oxygen
which is obligate anaerobic?

facultatively anaerobic because it can either grow with or without oxygen
what do we call the third type of bacteria?

4- because it needs only a small amount of O2 to grow, so it stays close to the top, but not at the very top
which bacteria is microaerophile?

- colonial morphology and color
- presence or absence of hemolysis on blood agar
- color with the gram stain
- motility- due to type of flagella
- ability to grow on macconkey agar
- reaction to the oxydation-fermentation test
- reaction in catalase and oxidase test
what are different ways to identify bacteria?
low molecular weight microbial metabolites that can kill or inhibit the growth of bacteria. they are natural, and produced by microorganisms.
what are antibiotics?
bactericidal
what is the type of antibiotic that kills bacteria?
bacteriostatic
what is the type of antibiotic that inhibits the growth or synthesis of the bacteria?
antibiotics+synthetic compounds
what is an antimicrobial agent?
antibiotics are produced naturally by microorganisms in the animals body, while antimicrobial agents are created by mixing antibiotics and synthetic compounds
what is the difference between an antibiotic and antimicrobial agent?
the ability of microorganisms to persist/grow in the presence of antimicrobial agents
what is antimicrobial resistance?
bacteria can become resistant
what is the problem with antimicrobial agents?
to determine the minimum inhibitory concentration (MIC) of an antimicrobial agent against a microorganism. the MIC is the lowest concentration of an antimicrobial drug that effectively inhibits the growth of the organism
what is the E-test used for?
the E-test.
it is used to determine the minimum inhibitory concentration of an antimicrobial agent against an organism
what type of test is being performed here?

1. mutates the receptor of the antibiotic
2. produces enzymes that modify the antibiotic
3. becomes impermeable so that the antibiotic cannot enter inside
4. expels the antibiotic after it enters its cytoplasm
what are 4 ways that the bacteria becomes resistant against the antibiotic?
1. vertical transmission- gene transmitted from parent to daughter cell
2. horizontal transmission- gene transmitted from one bacteria to another of the same generation. 3 types:
- transformation: one bacteria dies and the gene passes to a nearby bacteria
-transduction: bacteriophages infect a bacteria
-conjugation: pilli attach bacteria and transfer the gene
what are the 2 ways that a bacteria can give resistance to another bacteria?
when genes are transmitted from the mother to the daughter bacteria cell
what is vertical transmission?
when genes are transmitted from a bacteria to another of the same generation.
what is horizontal transmission?